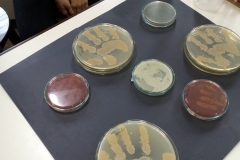
3SCI CLUB VISIT

WELCOME TO PTVEM SECONDARY SECTION SCHOOL
Activities

Studies alone do not make a complete student, so along with academics we encourage their creative mind too and give them a platform to showcase their talents through different activities.
We have vertically divided the students in to four houses and called them as J. C. Bose, C.V. Raman, Kusumagraj and Premchand. This is to encourage healthy competition among students. Inter house debates, dramas, singing competitions are held. Inter-house volley ball matches, cricket matches, relay races are a hallmark of the school. The Head Boy and Head Girl are selected by a panel of teachers. House Commanders are elected by students through secret ballot.
Different clubs are formed to cater to particular interest and talents of the students.
‘Eureka’ our science club provides answers to a lot of ‘whys’ in the students mind. No wonder our school has won prestigious prizes at state level in Science projects. National science day celebrated every year.
Marathi Vangamaya Mandal encouraged those pupils who want to vent out their sentiments and emotions in their mother tongue. Marathi Rajbhasha din celebrated every year.
Consumer club makes them aware of their rights and duties and teaches how to defend themselves from being cheated.
Our school coaches students in volley ball and cricket. Our Volley ball team has reached up to the state level. In cricket, in the under 14 category our pupils have reached the Giles Shield finals.
Social Service: The students extend a helping hand to the unfortunates and destitutes. They contribute and go to do social service to the orphanages and institutions for mentally challenged.
Our school’s motto is नहि ज्ञानेन सदृशं पवित्रमिह विद्यते We, at Parle Tilak Vidyalaya English Medium School, inculcate values given to us by our forefathers and we will see that this torch is passed on to our future students.
Science Club(Eureka) :
SCIENCE CLUB MEMBERS OF STD 8TH VISITED IISER PUNE
SCIENCE CLUB MEMBERS OF STD 9TH VISITED MITHIBAI COLLEGE MICROBIOLOGY DEPARTMENT
FIRST AID TRAINING PROGRAMME FOR STD 9TH SCIENCE CLUB MEMBERS ORGANISED BY JUNIOR RED CROSS SOCIETY
Co-curricular Activities (Work Shop):
Interact Club :
Interact Club which is the partner in service with Rotary Club trains students in leadership quality.
Nature Club (young Explorer) :
For Nature lovers and future activist to save environment, we have the Nature Club. Our School’s Nature Club ‘Young Explorers’ has won the best Nature Club award almost every year.